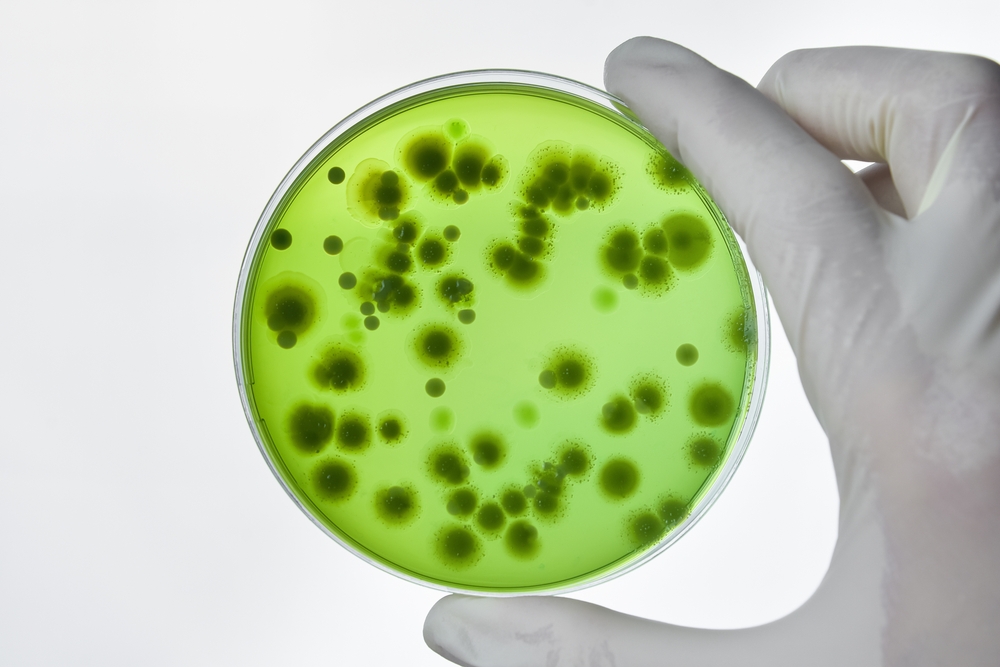
ស្រ្តីអង់គ្លេសម្នាក់ស្ទើរតែបាត់បង់ជីវិតក្រោយឆ្លងដោយបាក់តេរីម្យ៉ាង

ស្ត្រីអង់គ្លេសម្នាក់ដែលមានវ័យ២៧ឆ្នាំ ស្ទើរតែបាត់បង់ជីវិតភ្លាមៗ បន្ទាប់ពីឆ្លងបាក់តេរីម្យ៉ាងឈ្មោះថា necrotizing Fasciitis ដែលជាបាក់តេរីស៊ីសាច់។ បើយោងតាមរបាយការណ៍របស់ប្រព័ន្ធផ្សព្វផ្សាយអង់គ្លេស អ្នកស្រី Charleigh Chatterton បានសម្រាលកូនស្រីម្នាក់ដោយពុំមានផលវិបាកណាមួយក្រោយសម្រាលឡើយ ប៉ុន្តែស្រាប់តែមានកន្ទួលលេចឡើងនៅលើពោះរបស់នាង ទើបត្រូវត្រឡប់មកកាន់មន្ទីរពេទ្យវិញ។
ស្រ្តីអង់គ្លេសម្នាក់ស្ទើរតែបាត់បង់ជីវិតក្រោយឆ្លងដោយបាក់តេរីម្យ៉ាង

ក្រោយធ្វើរោគវិនិច្ឆ័យ ក្រុមគ្រូពេទ្យរកឃើញថា អ្នកស្រីបានឆ្លងបាក់តេរី necrotizing Fasciitis និងមានឱកាសរស់តិចតួចបំផុត។ អំឡុងពេលដែលក្រុមគ្រូពេទ្យបានធ្វើតេស្ដ ស្ថានភាពសុខភាពរបស់ស្ត្រីរូបនេះ គឺកាន់តែយ៉ាប់យ៉ឺន និងមិនដឹងខ្លួន។ ការឆ្លងបាក់តេរីមួយប្រភេទនេះ តម្រូវឲ្យស្ត្រីរូបនោះត្រូវធ្វើការវះកាត់បន្ទាន់ ដើម្បីយកជាលិកាដែលងាប់ចេញយ៉ាងច្រើន និងបញ្ឈប់បាក់តេរីស៊ីសាច់កុំឲ្យរាលដាលបន្ថែមទៀត។
រោគសញ្ញារបស់ស្ត្រីអង់គ្លេស
- កន្ទួលនៅលើពោះ
- នៅពេលដែលប៉ះត្រង់កន្ទួលនោះ សីតុណ្ហភាពរាងកាយចាប់ផ្តើមក្តៅខ្លាំង
- សន្លប់មិនដឹងខ្លួន។
ការឆ្លងបាក់តេរី Necrotizing Fasciitis
បាក់តេរី Necrotizing Fasciitis មិនមែនជាករណីកម្រខ្លាំងនោះឡើយ។ បើយោងតាមការស្ទង់មតិមួយ បានបង្ហាញថា មានមនុស្សប្រហែលជា៥០០នាក់នៅប្រទេសអង់គ្លេស បានឆ្លងបាក់តេរីមួយនេះ ជារៀងរាល់ឆ្នាំ។ តើបាក់តេរីនេះជាអ្វី? ហើយប៉ះពាល់ដល់មនុស្សដោយរបៀបណា?
- បាក់តេរីនេះប៉ះពាល់ដល់ជាលិកាដែលស្ថិតនៅក្រោមស្បែក
- អាចបណ្តាលឲ្យមានរបួសស្រាល
- បើមិនព្យាបាលភ្លាមៗទេនោះ អាចគ្រោះថ្នាក់ដល់អាយុជីវិត
- រោគសញ្ញាអាចស្រដៀងទៅនឹងជំងឺគ្រុនផ្ដាសាយធំ ឬកន្ទួល និងហើមនៅតាមផ្នែកផ្សេងៗនៃរាងកាយ
- អាចវិលមុខ និងវង្វេងស្មារតី។
ចុងក្រោយ បញ្ហាឆ្លងបាក់តេរីនេះ អាចវិវត្តន៍ទៅមុខយ៉ាងឆាប់រហ័ស ហើយថែមទាំងអាចបង្កឲ្យមានបញ្ហាសុខភាពធ្ងន់ធ្ងរ ដូចជាការបង្ករោគក្នុងឈាម និងខ្សោយសរីរាង្គថែមទៀតផង។

ការឆ្លងបាក់តេរីនេះបណ្តាលមកពីអ្វី?
ការឆ្លងបាក់តេរីអាចជ្រាបចូលទៅក្នុងរាងកាយតាមរយៈ៖
- ការមុត និងរលាត់ស្បែក
- ការរលាក
- សត្វល្អិតទិច
- ការវះកាត់
- ការចាក់ថ្នាំ។
អ្នកដែលស្ថិតក្នុងហានិភ័យខ្ពស់នៃការឆ្លងជំងឺនេះ គឺអ្នកដែលមានជំងឺទឹកនោមផ្អែម ឬមានប្រព័ន្ធភាពស៊ាំខ្សោយ។
អត្ថបទគួរអាន៖
- ប្រើអាល់កុលដឺក្រេខ្ពស់ មិនអាចសម្លាប់មេរោគបាន ហើយគ្រោះថ្នាក់ស្បែកទៀត!
- លាងដៃនឹងអាល់កុលញឹកញាប់ធ្វើឲ្យស្ងួត រលាកដៃ គួរធ្វើបែបណា?
- កាំកុងត្រូលរកឃើញអាល់កុលលក់លើទីផ្សារ ភាគច្រើនមានមេតាណុលខ្ពស់ បង្កគ្រោះថ្នាក់ចំពោះសុខភាព
- ជំទាវ ឱ វណ្ណឌីន ណែនាំវិធីលាងដៃមិនឲ្យរបក ស្ងួត ប្រេះ
- កុំចាញ់បោក! កន្សែងសើមមិនអាចសម្លាប់ COVID-19 បានទេ
- អាល់កុលមេតាណុលអាចសម្លាប់វីរុស COVID-19 បានអត់?
បដិសេធ
Hello Health Group និង “Hello គ្រូពេទ្យ” មិនចេញវេជ្ជបញ្ជា មិនធ្វើរោគវិនិច្ឆ័យ ឬព្យាបាលជូនទេ៕
Necrotising fasciitis
https://www.nhs.uk/conditions/necrotising-fasciitis/
Necrotizing Fasciitis
https://rarediseases.org/rare-diseases/necrotizing-fasciitis/
Get the facts about necrotizing fasciitis: The flesh-eating disease
https://apic.org/monthly_alerts/get-the-facts-about-necrotizing-fasciitis-the-flesh-eating-disease/
កំណែប្រែបច្ចុប្បន្ន
01/06/2023
អត្ថបទដោយ នូ សោភ័ណ្ឌ
ត្រួតពិនិត្យដោយ វេជ្ជ. ចាន់ ស៊ីណេត
បច្ចុប្បន្នភាពដោយ៖ Sopheng
ត្រួតពិនិត្យដោយ
វេជ្ជ. ចាន់ ស៊ីណេត
ឯកទេសសម្ភព និងរោគស្ត្រី · មន្ទីរពេទ្យបង្អែកមិត្តភាពកម្ពុជា-ចិន សែនសុខ